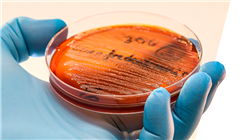

University certificate
The world's largest faculty of pharmacy”
Introduction to the Program
This 100% online Postgraduate certificate will provide you with specialized and updated knowledge on the epidemiology, pathogenesis, diagnosis and treatment of Multidrug-Resistant Gram Negative Bacteria”

Gram Negative Bacteria have developed resistance to multiple classes of antibiotics, seriously complicating the treatment of common and potentially life-threatening infections. This problem not only increases morbidity and mortality among patients, but also imposes a significant burden on healthcare systems, urgently demanding innovative prevention and control strategies to contain their spread.
This is how this Postgraduate certificate is born, which will comprehensively address every key aspect of these emerging infections. In this sense, it will delve into the various dimensions of infections by Gram-negative microorganisms, starting with the epidemiology, both in community and nosocomial settings. In addition, the critical relevance of multidrug-resistant infections will be analyzed, highlighting their impact on public health and the need for effective management strategies.
In addition, the pathogenesis of these infections will be discussed, examining the specific factors, both of the microorganism and the patient, that influence their development. We will also investigate the methodologies for clinical evaluation and the importance of complementary tests, such as blood tests, imaging and microbiological techniques in the diagnosis, and the optimal management of these complex infections.
Finally, the estimation of severity and risk of acquisition will be covered, introducing traditional and new tools to assess and predict the severity of these infections. Likewise, a complete section will be devoted to empirical and targeted treatment, discussing the microorganisms involved, adjustments according to microbiological results and the management of side effects of antibiotherapy. In short, professionals will be immersed in the functioning of the Optimization of Antimicrobial Use (PROA) teams and their crucial role in promoting the rational use of antibiotics.
In this way, TECH has launched a complete and fully online university program, accessible through any electronic device connected to the Internet. In addition, it is supported by the innovative Relearning methodology, which focuses on the repeated review of key concepts to ensure an effective and fluent understanding of the contents.
Bet on TECH! You will be prepared to address emerging challenges in antimicrobial resistance, promoting rational use of antibiotics and improving public health outcomes globally”
This Postgraduate certificate in Multidrug-Resistant Gram Negative Bacteria contains the most complete and up-to-date scientific program on the market. The most important features include:
- The development of practical cases presented by experts in Pharmacy
- The graphic, schematic and eminently practical contents with which it is conceived gather scientific and practical information on those disciplines that are indispensable for professional practice
- Practical exercises where the self-assessment process can be carried out to improve learning
- Its special emphasis on innovative methodologies
- Theoretical lessons, questions to the expert, debate forums on controversial topics, and individual reflection assignments
- Content that is accessible from any fixed or portable device with an Internet connection
You will address optimal duration of antibiotherapy, challenges associated with side effects, and management of Program Optimization of Antibiotics (PROA) teams. What are you waiting for to enroll?"
The program’s teaching staff includes professionals from the field who contribute their work experience to this educational program, as well as renowned specialists from leading societies and prestigious universities.
The multimedia content, developed with the latest educational technology, will provide the professional with situated and contextual learning, i.e., a simulated environment that will provide immersive education programmed to learn in real situations.
This program is designed around Problem-Based Learning, whereby the professional must try to solve the different professional practice situations that arise during the course. For this purpose, students will be assisted by an innovative interactive video system created by renowned and experienced experts.
You will delve into the epidemiological characteristics of Gram-negative microorganisms, highlighting community and nosocomial infections, through the best didactic materials, at the forefront of technology"

You will emphasize the importance of a rigorous clinical evaluation, including advanced anamnesis techniques and other complementary tests, thanks to an extensive library of multimedia resources"
Syllabus
From epidemiology and pathogenesis, to clinical diagnosis and therapeutic strategies, the academic program will examine in detail the risk factors associated with Multidrug-Resistant Gram Negative Bacteria, the differences between nosocomial and community infections, and the critical importance of identifying and managing multidrug-resistant strains. In addition, emphasis will be placed on advanced laboratory techniques, such as microbiological and imaging tests, along with the evaluation of the severity of infections and the rational use of antibiotics.

This Postgraduate certificate will cover a wide range of specialized content, designed to provide a comprehensive and up-to-date understanding of Multidrug-Resistant Gram Negative Bacteria”
Module 1. Multidrug-Resistant Gram Negative Bacteria
1.1. Infections Due to Gram-Negative Microorganisms
1.1.1. Epidemiology of Gram-Negative Microorganisms
1.1.2. Community and Nosocomial Infections by Gram-Negative Microorganisms
1.1.3. Relevance of Infections by Multidrug-Resistant Gram-Negative Microorganisms
1.2. Pathogenesis of Infections by Gram-Negative Microorganisms
1.2.1. Factors Related to Gram-Negative Microorganisms
1.2.2. Patient Factors in Gram-Negative Infections
1.2.3. Other Factors in Gram-Negative Infections
1.3. Clinical Evaluation of Patients with Multidrug-Resistant Gram-Negative Infections
1.3.1. Medical History
1.3.2. Clinical Evaluation of Patients
1.3.3. Other Data of Interest
1.4. Complementary Tests in Infections by Multidrug-Resistant Gram-Negative Microorganisms
1.4.1. Blood Tests
1.4.2. Imaging Tests
1.4.3. Microbiological Techniques
1.5. Estimation of Severity in Patients with Infections by Multidrug-Resistant Gram-Negative Microorganisms
1.5.1. Gram-Negative Multidrug-Resistant Microorganisms
1.5.2. Traditional Approach to Severity Estimation
1.5.3. Practical Conclusions
1.6. Risk of Acquiring Infections by Multidrug-Resistant Gram-Negative Microorganisms
1.6.1. Clinical Factors in the Acquisition of Infections by Multidrug-Resistant Gram-Negative Microorganisms
1.6.2. Other Factors in the Acquisition of Infections by Multidrug-Resistant Gram-Negative Microorganisms
1.6.3. Tools to Calculate the Risk of Presence of Multidrug-Resistant Gram-Negative Microorganisms
1.7. Empirical Treatment in the Suspicion of Infections by Multidrug-Resistant Gram-Negative Microorganisms
1.7.1. Microorganisms Involved According to Localization
1.7.2. Comprehensive Assessment of Patients with Suspected Infections by Multidrug-Resistant Gram-Negative Microorganisms
1.7.3. Selection of Empirical Antibiotic Treatment
1.8. Targeted Therapy in Infections by Multidrug-Resistant Gram-Negative Microorganisms
1.8.1. Adjustment of Antibiotic Therapy According to Microbiological Results
1.8.2. Follow-up of Multidrug-Resistant Gram-Negative Microorganism Infection
1.8.3. Most Relevant Side Effects of Antibiotherapy
1.9. Duration of Antibiotherapy in Infections by Multidrug-Resistant Gram-Negative Microorganisms
1.9.1. Estimation of the Duration of Antibiotic Treatment in Infections by Multidrug-Resistant Gram-Negative Microorganisms
1.9.2. Relevance of Focus Control in Infections by Multidrug-Resistant Gram-Negative Microorganisms
1.9.3. Special Considerations Related to Antibiotic Therapy in These Infections
1.10. PROA Teams in Infections Caused by Multidrug-Resistant Gram-Negative Microorganisms
1.10.1. PROA Teams: History
1.10.2. Impact of PROA Teams on the Correct Use of Antibiotic Treatments
1.10.3. Challenge of PROA Teams in the Treatment of Infections Caused by Multidrug-Resistant Gram-Negative Microorganisms
This comprehensive university program will prepare pharmacists to effectively address these challenges in daily clinical practice, hand-in-hand with the world's best digital university, according to Forbes”
Postgraduate Certificate in Multidrug-Resistant Gram Negative Bacteria
Looking to acquire advanced knowledge in the management of infections caused by Gram-negative bacteria resistant to multiple antibiotics? You are in the right place. At TECH Global University you will find a complete Postgraduate Certificate that will help you achieve your academic goals. This program, offered 100% online, provides an in-depth understanding of the challenges posed by these bacteria in the clinical setting and the most effective strategies for their treatment and control. During the course, you will explore the specific resistance mechanisms of Gram-negative bacteria such as Escherichia coli, Klebsiella pneumoniae and Pseudomonas aeruginosa, among others. In addition, key topics such as identification and characterization of multidrug-resistant strains, rational use of antimicrobials and best practices in infection prevention and control in hospital and community settings will be addressed. An outstanding feature of this course is its focus on the practical application of the knowledge acquired. Thus, you will learn to interpret advanced microbiological tests, design personalized therapeutic schemes and apply infection control measures based on the latest evidence. In addition, you will delve into the use of new technologies and innovative approaches to deal with infections caused by multidrug-resistant Gram-negative bacteria.
Get your degree with a Postgraduate Certificate in Multidrug-Resistant Gram Negative Bacteria
The online mode of the course offers flexibility and accessibility, allowing you to access the content from anywhere and at convenient times. Through an advanced educational platform, you will benefit from interactive resources and didactic material, which will enrich your learning experience. The course is led by a team of professionals with extensive experience in the management of multidrug-resistant Gram-negative infections. These experts will provide specialized guidance and ongoing support throughout the program, ensuring that you receive high quality training relevant to the current demands of the healthcare field. Enrolling in this Postgraduate Certificate is a strategic decision for healthcare professionals who wish to specialize in the management of complex infections and contribute to the advancement of antimicrobial resistance control. This advanced program provides the tools and knowledge necessary to effectively address the challenge of multidrug-resistant Gram-negative bacteria in the clinical setting.